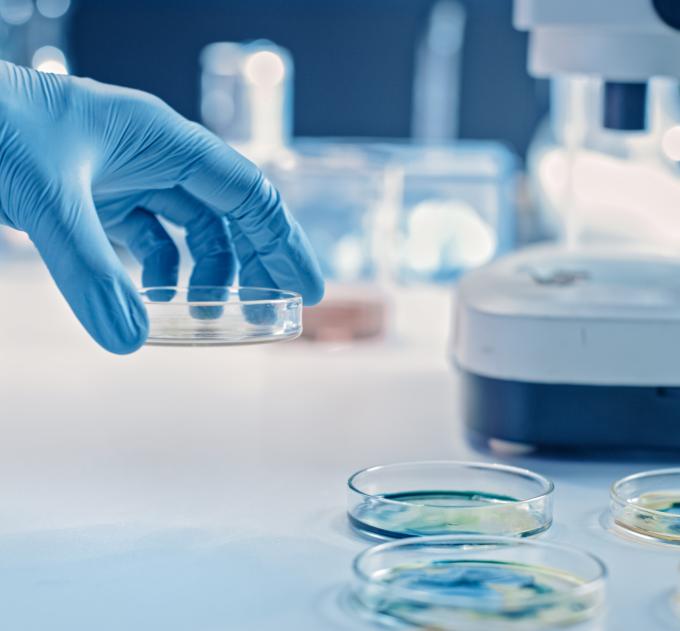
Scientist Works with Petri Dishes with Various Bacteria, Tissue and Blood Samples.

Strong fundamental research is a cornerstone of innovation, and key to healthy people, societies, ecosystems and economies. UBC Science researchers have played a major role in the University's success in technology transfer and commercialization, and are committed to partnerships that centre community needs and interests. Explore industry facing and collaborative opportunities across the Faculty.
Musqueam First Nation land acknowledegement
We honour xwməθkwəy̓ əm (Musqueam) on whose ancestral, unceded territory UBC Vancouver is situated. UBC Science is committed to building meaningful relationships with Indigenous peoples so we can advance Reconciliation and ensure traditional ways of knowing enrich our teaching and research.
Learn more: Musqueam First Nation
Faculty of Science
Office of the Dean, Earth Sciences Building2178–2207 Main Mall
Vancouver, BC Canada
V6T 1Z4